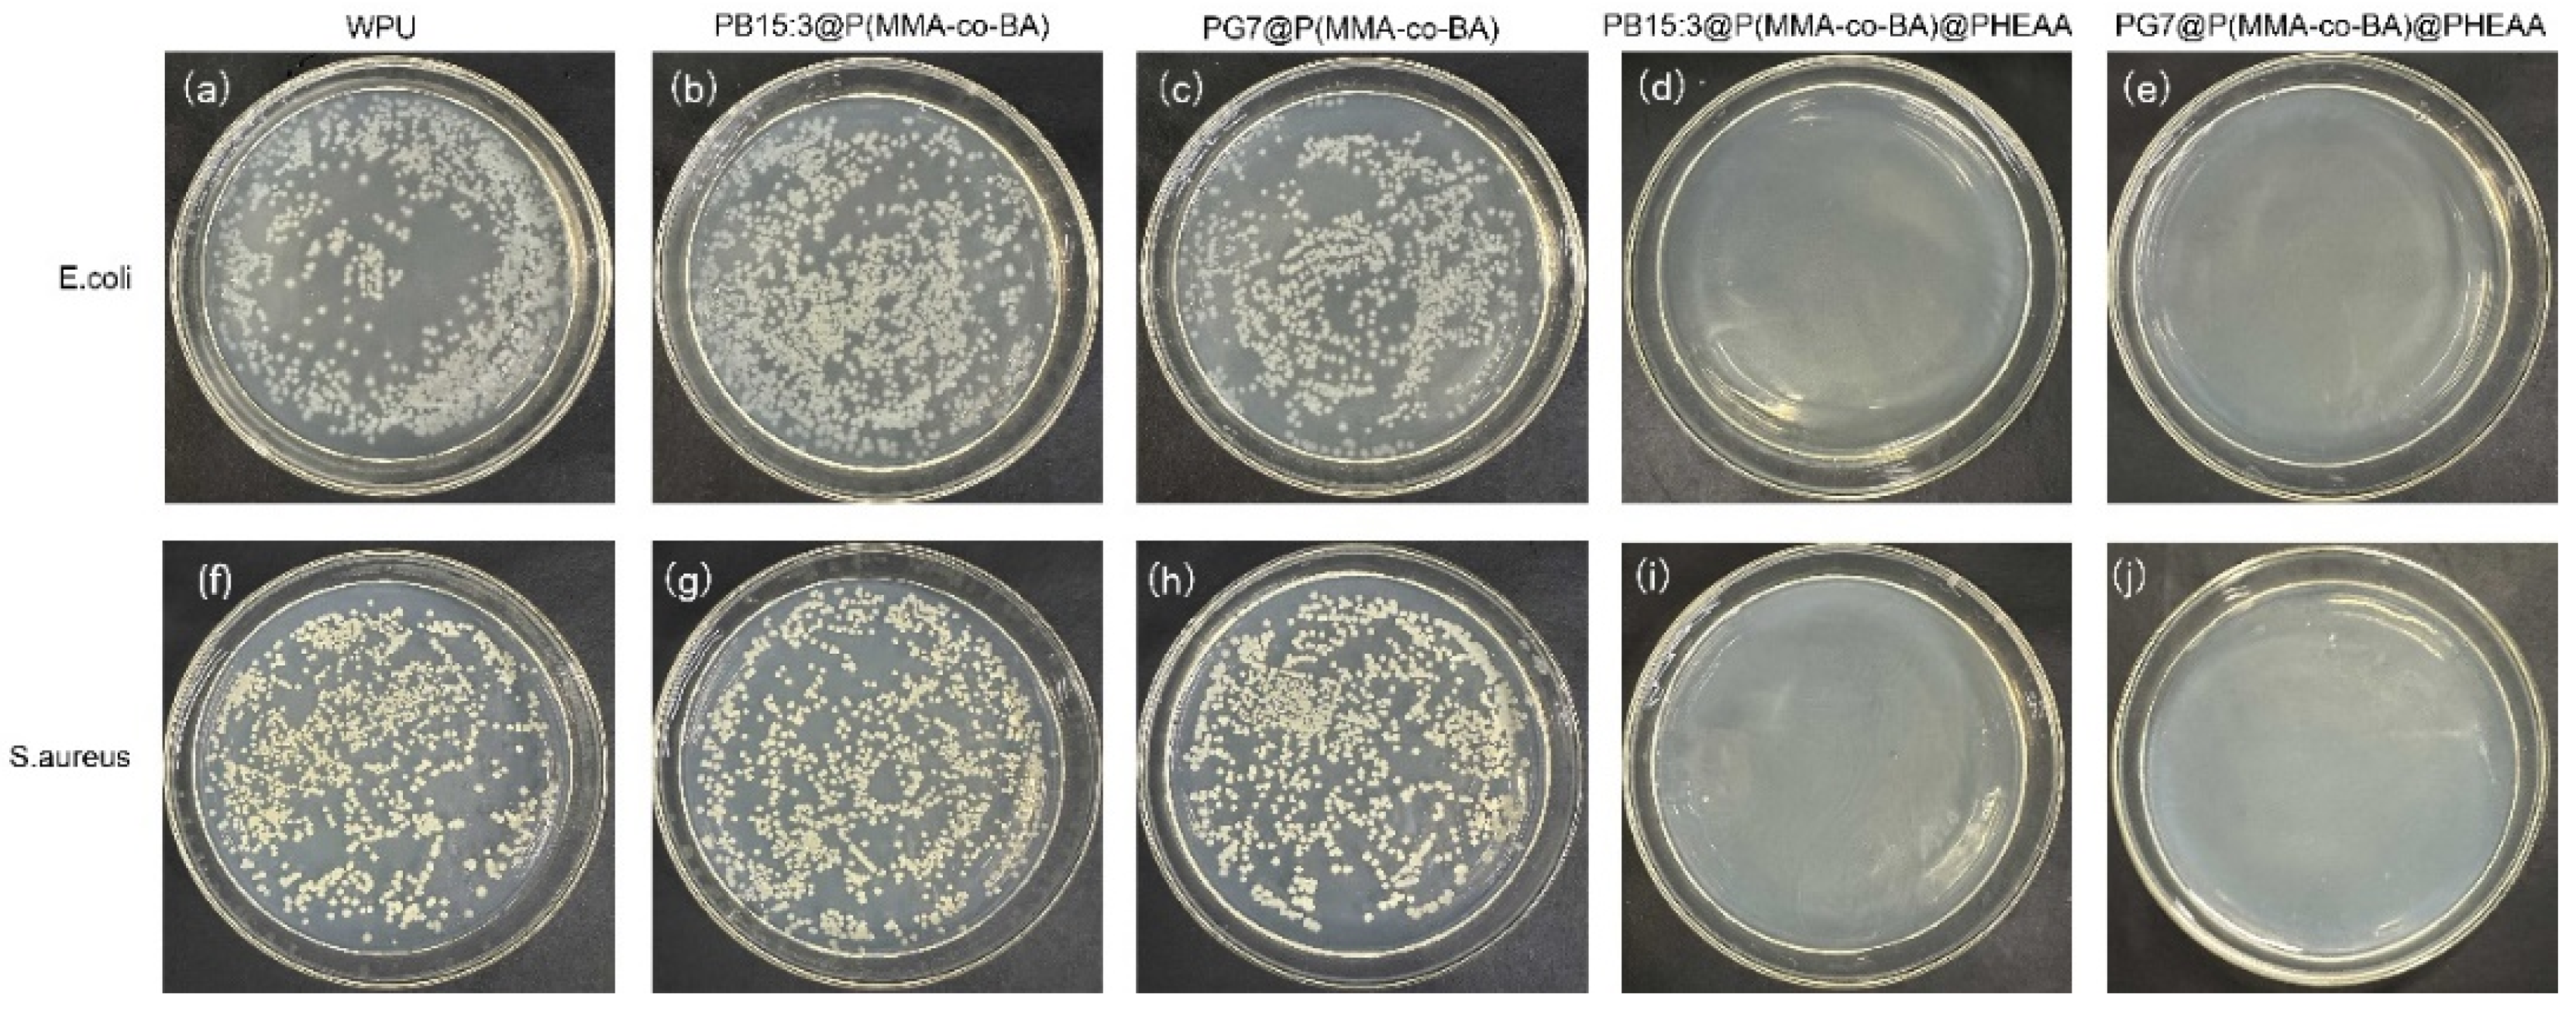
Coatings 13 01114 g007

The Design and Preparation of Antibacterial Polymer Brushes with Phthalocyanine Pigments
Abstract
1. Introduction
2. Materials and Methods
2.1. Materials
2.2. Preparation of Pigment Composite Latexes
2.3. Preparation of Antibacterial Pigment Composite Latexes
2.4. Characterization
2.4.1. Dynamic Light Scattering (DLS)
2.4.2. Zeta Potential
2.4.3. Centrifugal Stability
2.4.4. Fourier-Transform Infrared Spectroscope (FTIR)
2.4.5. Transmission Electron Microscope (TEM)
2.4.6. Thermogravimetric Analysis (TGA)
2.4.7. Chromaticity
2.5. Antibacterial Experiment
3. Results and Discussion
3.1. Preparation of Pigment Composites Latexes
3.2. Preparation of Functionalized Composite Latexes
3.3. Chromaticity of Functionalized Composite Latexes
3.4. Antibacterial Performance of Functionalized Composite Latexes
4. Conclusions
Author Contributions
Funding
Institutional Review Board Statement
Informed Consent Statement
Data Availability Statement
Conflicts of Interest
References
- Ding, Y.Y.; Ye, M.Q.; Han, A.J.; Zang, Y. Preparation and characterization of styrene-acrylic resin encapsulated CI Pigment Yellow 17 and charge control agent multicomponent particles. J. Coat. Technol. Res. 2018, 15, 315–324. [Google Scholar] [CrossRef]
- El-sayed, G.M.; Kamel, M.M.; Morsy, N.S.; Taher, F.A. Encapsulation of nano Disperse Red 60 via modified miniemulsion polymerization. I. Preparation and characterization. J. Appl. Polym. Sci. 2012, 125, 1318–1329. [Google Scholar] [CrossRef]
- Hakeim, O.A.; Arafa, A.A.; Zahran, M.K.; Abdou, L.A.W. Effect of process conditions on the properties of surface-modified organic pigments encapsulated by UV-curable resins. Color. Technol. 2018, 134, 44–58. [Google Scholar] [CrossRef]
- Li, J.J.; Fan, J.L.; Cao, R.; Zhang, Z.; Du, J.J.; Peng, X.J. Encapsulated Dye/Polymer Nanoparticles Prepared via Miniemulsion Polymerization for Inkjet Printing. ACS Omega 2018, 3, 7380–7387. [Google Scholar] [CrossRef]
- Zhang, C.Y.; Li, J.W.; Cui, N.N.; Yan, X.F.; Xie, Z.W.; Qi, D.M. Polymer/CI Pigment Red 170 hybrid latexes prepared by RAFT-mediated surfactant-free emulsion polymerization. Colloid Surf. A Physicochem. Eng. Asp. 2021, 629, 11. [Google Scholar] [CrossRef]
- Haroun, A.A.; Diab, H.A.; Hakeim, O.A. Cellulosic fabrics printing with multifunctional encapsulated phthalocyanine pigment blue using phase separation method. Carbohydr. Polym. 2016, 146, 102–108. [Google Scholar] [CrossRef] [PubMed]
- Fu, S.H.; Xu, C.H.; Du, C.S.; Tian, A.L.; Zhang, M.J. Encapsulation of CI Pigment blue 15:3 using a polymerizable dispersant via emulsion polymerization. Colloid Surf. A Physicochem. Eng. Asp. 2011, 384, 68–74. [Google Scholar] [CrossRef]
- Hakeim, O.A.; Diab, H.A.; Adams, J. Preparation and characterization of UV curable-encapsulated phthalocyanine blue pigment. Prog. Org. Coat. 2015, 84, 70–78. [Google Scholar] [CrossRef]
- Hakeim, O.A.; Arafa, A.A.; Zahran, M.K.; Abdou, L.A.W. UV-curable encapsulation of surface Modified organic pigments for inkjet printing of textiles. Colloid Surf. A Physicochem. Eng. Asp. 2014, 447, 172–182. [Google Scholar] [CrossRef]
- He, J.J.; Luo, Y. Novel carboxylate comb-like dispersant used in disperse dyes. J. Appl. Polym. Sci. 2022, 139, 11. [Google Scholar] [CrossRef]
- Elgammal, M.; Schneider, R.; Gradzielski, M. Development of self-curable hybrid pigment inks by miniemulsion polymerization for inkjet printing of cotton fabrics. Dyes Pigment. 2016, 133, 467–478. [Google Scholar] [CrossRef]
- Li, M.; Zhang, L.P.; Peng, H.Y.; Fu, S.H. Preparation of fluorescent pigment latex and its application on binder-free printing of cotton fabrics. J. Appl. Polym. Sci. 2018, 135, 9. [Google Scholar] [CrossRef]
- Wen, T.; Meng, X.W.; Li, Z.Y.; Ren, J.; Tang, F.Q. Pigment-based tricolor ink particles via mini-emulsion polymerization for chromatic electrophoretic displays. J. Mater. Chem. 2010, 20, 8112–8117. [Google Scholar] [CrossRef]
- Zhao, J.; Millians, W.; Tang, S.D.; Wu, T.H.; Zhu, L.; Ming, W.H. Self-Stratified Antimicrobial Acrylic Coatings via One-Step UV Curing. ACS Appl. Mater. Interfaces 2015, 7, 18467–18472. [Google Scholar] [CrossRef] [PubMed]
- Shevtsova, T.; Cavallaro, G.; Lazzara, G.; Milioto, S.; Donchak, V.; Harhay, K.; Korolko, S.; Budkowski, A.; Stetsyshyn, Y. Temperature-responsive hybrid nanomaterials based on modified halloysite nanotubes uploaded with silver nanoparticles. Colloid Surf. A Physicochem. Eng. Asp. 2022, 641, 128525. [Google Scholar] [CrossRef]
- Liu, X.C.; Xu, Y.S.; Wang, X.H.; Shao, M.F.; Xu, J.; Wang, J.; Li, L.; Zhang, R.; Guo, X.H. Stable and efficient loading of silver nanoparticles in spherical polyelectrolyte brushes and the antibacterial effects. Colloid Surf. B Biointerfaces 2015, 127, 148–154. [Google Scholar] [CrossRef]
- Bai, S.; Li, X.H.; Zhao, Y.H.; Ren, L.X.; Yuan, X.Y. Antifogging/Antibacterial Coatings Constructed by N-Hydroxyethylacrylamide and Quaternary Ammonium-Containing Copolymers. ACS Appl. Mater. Interfaces 2020, 12, 12305–12316. [Google Scholar] [CrossRef] [PubMed]
- Galie, S.; Garcia-Gutierrez, C.; Miguelez, E.M.; Villar, C.J.; Lombo, F. Biofilms in the Food Industry: Health Aspects and Control Methods. Front. Microbiol. 2018, 9, 18. [Google Scholar] [CrossRef] [PubMed]
- Zhang, C.; Cui, F.; Zeng, G.M.; Jiang, M.; Yang, Z.Z.; Yu, Z.G.; Zhu, M.Y.; Shen, L.Q. Quaternary ammonium compounds (QACs): A review on occurrence, fate and toxicity in the environment. Sci. Total Environ. 2015, 518, 352–362. [Google Scholar] [CrossRef]
- Yan, S.J.; Song, L.J.; Luan, S.F.; Xin, Z.R.; Du, S.S.; Shi, H.C.; Yuan, S.S.; Yang, Y.M.; Yin, J.H. A hierarchical polymer brush coating with dual-function antibacterial capability. Colloid Surf. B Biointerfaces 2017, 150, 250–260. [Google Scholar] [CrossRef]
- Liu, T.W.; Yan, S.J.; Zhou, R.T.; Zhang, X.; Yang, H.W.; Yan, Q.Y.; Yang, R.; Luan, S.F. Self-Adaptive Antibacterial Coating for Universal Polymeric Substrates Based on a Micrometer-Scale Hierarchical Polymer Brush System. ACS Appl. Mater. Interfaces 2020, 12, 42576–42585. [Google Scholar] [CrossRef] [PubMed]
- Ng, G.; Li, M.X.; Yeow, J.; Jung, K.; Pester, C.W.; Boyer, C. Benchtop Preparation of Polymer Brushes by SI-PET-RAFT: The Effect of the Polymer Composition and Structure on Inhibition of a Pseudomonas Biofilm. ACS Appl. Mater. Interfaces 2020, 12, 55243–55254. [Google Scholar] [CrossRef] [PubMed]
- Zhao, C.; Patel, K.; Aichinger, L.M.; Liu, Z.Q.; Hu, R.D.; Chen, H.; Li, X.S.; Li, L.Y.; Zhang, G.; Chang, Y.; et al. Antifouling and biodegradable poly(N-hydroxyethyl acrylamide) (polyHEAA)-based nanogels. Rsc Adv. 2013, 3, 19991–20000. [Google Scholar] [CrossRef]
- Qin, X.; Chen, K.M.; Cao, L.; Zhang, Y.; Li, L.; Guo, X.H. Antifouling performance of nano-sized spherical poly(N-hydroxyethyl acrylamide) brush. Colloid Surf. B Biointerfaces 2017, 155, 408–414. [Google Scholar] [CrossRef]
- Fu, E.Y.; Chen, K.M.; Wang, Q.L.; Zhang, Y.; Yan, N.N.; Liu, L. Formation and stabilization of Pickering emulsions using salt-sensitive core-shell cationic nanoparticles. J. Mater. Sci. 2021, 56, 14019–14034. [Google Scholar] [CrossRef]

| Samples | Diameter (nm) | Centrifugal Stability (R) |
|---|---|---|
| PB15:3 | 160 | 6.9% |
| PB15:3 P(MMA-co-BA) | 141 | 49.0% |
| PG7 | 224 | 20.6% |
| PG7@P(MMA-co-BA) | 148 | 38.7% |
Disclaimer/Publisher’s Note: The statements, opinions and data contained in all publications are solely those of the individual author(s) and contributor(s) and not of MDPI and/or the editor(s). MDPI and/or the editor(s) disclaim responsibility for any injury to people or property resulting from any ideas, methods, instructions or products referred to in the content. |
© 2023 by the authors. Licensee MDPI, Basel, Switzerland. This article is an open access article distributed under the terms and conditions of the Creative Commons Attribution (CC BY) license (https://creativecommons.org/licenses/by/4.0/).
Share and Cite
Zhou, Y.; Chen, K.; Liu, L.; Wen, S.; Gui, T. The Design and Preparation of Antibacterial Polymer Brushes with Phthalocyanine Pigments. Coatings 2023, 13, 1114. https://doi.org/10.3390/coatings13061114
Zhou Y, Chen K, Liu L, Wen S, Gui T. The Design and Preparation of Antibacterial Polymer Brushes with Phthalocyanine Pigments. Coatings. 2023; 13(6):1114. https://doi.org/10.3390/coatings13061114
Chicago/Turabian StyleZhou, Yu, Kaimin Chen, Li Liu, Shaoguo Wen, and Taijiang Gui. 2023. "The Design and Preparation of Antibacterial Polymer Brushes with Phthalocyanine Pigments" Coatings 13, no. 6: 1114. https://doi.org/10.3390/coatings13061114
APA StyleZhou, Y., Chen, K., Liu, L., Wen, S., & Gui, T. (2023). The Design and Preparation of Antibacterial Polymer Brushes with Phthalocyanine Pigments. Coatings, 13(6), 1114. https://doi.org/10.3390/coatings13061114

